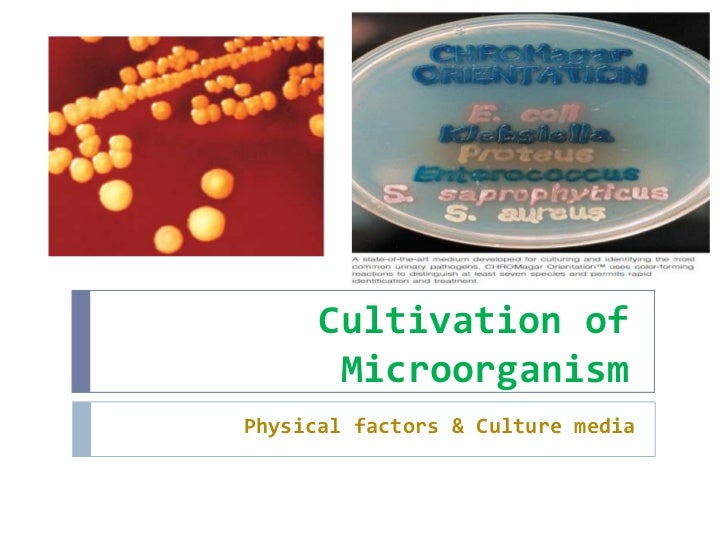
Cultivation of microorganism

If you are looking for PPT - Introduction to mycology PowerPoint Presentation, free download you've visit to the right place. We have 9 Pictures about PPT - Introduction to mycology PowerPoint Presentation, free download like nanoHUB.org - Resources: Challenges in Food Safety and Potential of, Cultivation, growth and nutrition of bacteria and also nanoHUB.org - Resources: Challenges in Food Safety and Potential of. Read more:
PPT - Introduction To Mycology PowerPoint Presentation, Free Download
 www.slideserve.com
www.slideserve.com fungi cultivation ppt mycology introduction growth requirements powerpoint presentation
Diagnosis Of Important Bacterial Diseases
 www.slideshare.net
www.slideshare.net bacterial diagnosis serological
Bacterial Culture Methods Ppt
 www.slideshare.net
www.slideshare.net bacterial
Bio Synthesis Of Nano Particles Using Bacteria
 www.slideshare.net
www.slideshare.net nano nanoparticles microbial
Cultivation, Growth And Nutrition Of Bacteria
 www.slideshare.net
www.slideshare.net cultivation bacteria
NanoHUB.org - Resources: Challenges In Food Safety And Potential Of
 nanohub.org
nanohub.org thank nanohub resources slides monitoring potential challenges labels safety smart presentation pause previous
Bacterial Culture Methods Ppt
 www.slideshare.net
www.slideshare.net bacterial bacteria culturing isolation
Bacterial Culture Methods Ppt
bacterial plating
Cultivation Of Microorganism
www.slideshare.net
www.slideshare.net cultivation microorganism slideshare culture
Fungi cultivation ppt mycology introduction growth requirements powerpoint presentation. Cultivation, growth and nutrition of bacteria. Diagnosis of important bacterial diseases